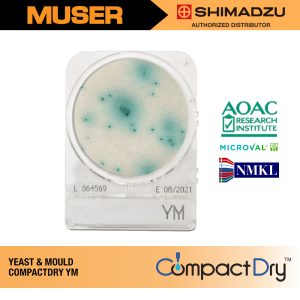
Shimadzu Diagnostics 54054 | Compact Dry YM

Nissui Pharmaceutical Malaysia Compact Dry
Nissui Pharmaceutical Malaysia offers a line of simple and easy dry medium for microbial count test called the Compact Dry. It is a solution over the conventional procedures which are complicated and time-consuming. Nissui Compact Dry is small in size with its solid dry media sterilised.
Nissui Compact Dry provides solution for a time-and-cost-saving microbial count which can be performed conveniently. By choosing Nissui Compact Dry, you can also reduce medical laboratory wastes which helps preserving our valuable resources.
Clinical Diagnostics, Microbiology, Quality Control, Tissue Culture, Food Hygiene and Environmental Testing, Pharmaceuticals, Research & Development, R&D, Health, Food Supplements.
Visit Nissui Pharmaceutical Website!
Showing all 6 results